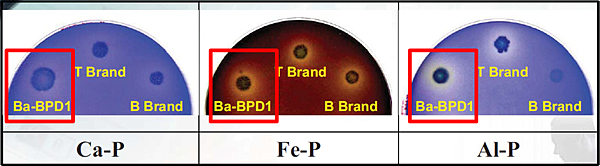
活力磷寶-溶磷效果

產品特性:
1. 主要菌種:液化澱粉芽孢桿菌BPD1 (Bacillus amyloliquefaciens - BPD1)。
2. 產品製程:以專一菌種、大豆蛋白、乳糖、糖蜜等有機資材經生物技術研製而成。
3. 產品特色:

圖中說明,液化澱粉芽孢桿菌可以幫助提高植物對真菌或細菌性病害的抵抗能力,是因為此菌種具有分泌伊枯草菌素(iturinA)、表面活性素(surfactin)與豐原素(fengycin)等抗生物質的能力;促進生長的部分,首先,此菌株可以分泌IAA與ACC(1-aminocyclopropane-1-carboxylic acid)去胺酵素(ACC deaminase)等促進作物生長的多項因子,另外可以分泌溶磷及螯鐵蛋白(siderophore),幫助植物吸收養分的能力,增加肥料的有效性。
4.使用方法:根據稀釋的倍數分成灌土、定植前的苗株浸泡(兩者的建議稀釋倍數為200~300倍)及葉面施肥(建議稀釋倍數為400~500倍)等三種。建議每週施用一次,早期(苗期)開始連續固定施用效果最佳,施用後可斟酌減少磷肥施用量。
5.注意事項:避免與銅劑類或抗生素殺菌劑一起施用。
溶磷效果介紹:
在營養生長初期,磷肥可以幫助植物的根系生長;進入生殖生長階段,可以促進植物開花,但是磷肥容易以磷酸鈣、磷酸鐵及磷酸鋁的形式固定在耕作土壤,導致作物對磷肥的吸收效果不佳,活力磷寶使用的菌種(Ba-BPD1),可以將這三種型態的磷素溶出來,且效果較其他菌種佳,更能幫助植物對磷肥的吸收。
圖二、活力磷寶與其他菌種溶磷效果比較
請先 登入 以發表留言。